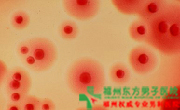
衣原体阳性是性病吗? 衣原体阳性是性病吗?

衣原体阳性是性病吗?衣原体是自然界中传播很广泛的病原体。其实衣原体阳性,主要是因为大量抗菌素导致了菌群失调而造成各种问题的出现。那么衣原体阳性是性病吗?福州东方男子男科专家说,一般来讲衣原体阳性主要是通过性接触传播,但也并非是所有衣原体阳性感染后都是性病。
衣原体是一种既不同于细菌也不同于病毒的一种微生物,属于原核生物,即细胞内没有形成核膜的细胞核。衣原体与细菌的主要区别是其缺乏合成生物能量来源的ATP酶,也就是说衣原体自己不能合成生物能量物质ATP,其能量完全依赖被感染的宿主细胞提供。而衣原体与病毒的主要区别在于其具有DNA、RNA两种核酸、核糖体和一个近似细胞壁的膜,并以二分裂方式进行增殖,能被抗生素抑制。衣原体属于原核类生物。>>>如有更多问题,请点击咨询在线男科专家
衣原体有两种存在形态,分别称为原体和始体。原体有感染力,它是一种不能运动的球状细胞。原体逐渐伸长,形成无感染力的个体,称为始体,这是一种薄壁的球状细胞,形体较大。衣原体成为造成非淋菌性尿道炎的重要因素,是在性混乱群体,由于他们往往有较高的性生活频率,性器官长期处于充血状态.这使得他们的性器官对病原体的抵抗力下降,他们就比正常人更容易出现支原体阳性感染,同时出现一些生殖器炎症,但并非是必是性病。如果您还想了解更多这方面的知识,欢迎来免费咨询福州东方男子医院的在线医生,他们会给您一个满意的答复的》》》